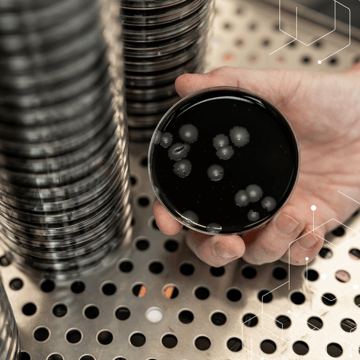
BLOG IMAGE SQUARE (12)

Reducing Healthcare-Associated Infections with AAMI ST108
- By: Dr. Michael Berg
- Tags: AAMI ST108, Building Sciences, Healthcare

Healthcare-Associated Infections (HAIs) are a major public health concern as they increase the length of hospital stays, healthcare costs, and mortality rates. During the COVID-19 pandemic, HAIs rose by 47% across all types of healthcare facilities and by 65% in intensive care units (ICUs). Thankfully, rates have dropped again, but the pandemic demonstrated just how vulnerable healthcare systems can be to opportunistic pathogens.
Improperly sterilized medical devices can contribute to HAIs as they can serve as a vehicle for transmitting harmful pathogens to patients. In this post, we take a closer look at AAMI ST108, the healthcare industry standard also known as Water for the Processing of Medical Devices, and how it helps to protect patients by preventing HAIs.
What is AAMI ST108?
AAMI ST108 aims to mitigate the risk of HAIs by providing guidelines for proper water quality and sterilization processes, emphasizing the critical role of effective cleaning and sterilization in preventing HAIs and ensuring patient safety. AAMI ST108 was created to provide healthcare facilities with clearer and more formalized guidance on water quality. As described in AAMI’s announcement, the standard:
- Identifies the categories of water quality that should be used during each stage of sterile processing.
- Provides a risk analysis and establishes roles and responsibilities for processing facilities.
- Assesses water quality based on factors such as pH, microbial level, conductivity, and other properties.
- Establishes maintenance, monitoring, and quality improvement procedures for water treatment systems.
- Addresses emergency circumstances such as service interruptions and boil water advisories.
What Types of Water Does AAMI ST108 Cover?
As noted in the formal title of the standard, Water for the Processing of Medical Devices, ST108 focuses on water used to clean and sterilize medical devices. Many of these devices can transmit pathogens into the bloodstream, so sterilization is key. AAMI ST108 also covers water used for cleaning as medical instruments often undergo an initial cleaning stage before sterilization. This water is also used for devices that do not require sterilization as the risk of transmission is low, e.g., blood pressure cuffs. The three categories of water are:
Utility – This water is used for general cleaning purposes, e.g., rinsing instruments before further processing, and typically comes directly from the tap. While baseline chemical and purity parameters need to be met, the overall water quality required is lower than the next two types of water.
Critical – This water is used to rinse certain types of medical devices after chemical sterilization. Devices that require chemical sterilization are typically those that cannot withstand the heat or moisture level used for steam sterilization. For example, some medical electronic devices are chemically sterilized using Ethylene Oxide (EtO) to eliminate all forms of microbial life, including spores. The water used to rinse these devices after treatment must be free of bacteria and endotoxins to avoid re-contaminating the device.
Steam – For those devices that can be sterilized using steam, this is typically the last processing stage. The devices are placed in an autoclave that uses steam, pressure, temperature, and time to destroy all microbes, including spores. The water used for autoclaving must typically meet the same standards as critical water, i.e., be free of bacteria and endotoxins.
AAMI ST108 does not cover water used for medical procedures, such as dialysis. The same organization has produced other standards, such as ANSI/AAMI 13959:2014 – Water for hemodialysis and related therapies, that covers water for these types of medical use.
What’s the Difference Between AAMI ST108 and TIR34?
There are some technical differences between AAMI ST108 and its predecessor, TIR34:2014, such as differentiating water into three categories instead of two. In addition, while TIR34 touches on the subject, AAMI ST108 takes a much more prescriptive and detailed approach to water management planning.
However, perhaps the most significant difference is in intent. TIR stands for Technical Information Report, and at its core, TIR34:2014 covered best practice recommendations. The “ST” in AAMI ST108 stands for Standard. While standards don’t have the same enforceability as law, not following them can have legal ramifications. For example, in a lawsuit involving an HAI, the healthcare facility may be asked to demonstrate that they followed the AAMI ST108 standard, and if they didn’t, why they chose not to. Furthermore, medical device manufacturers involved in the matter could point to the facility’s non-adherence to absolve themselves of liability.
How Pace® Can Help
Pace® has been providing water quality testing services and guidance to healthcare organizations and other professionals for more than three decades. We are experts in testing for organic and inorganic contaminants as well as waterborne pathogens in potable and non-potable water. In addition, we offer a comprehensive suite of water management planning services.
Over the years, our experts have helped numerous facilities adhere to such critical standards as ASHRAE 188 and those recommended by the Joint Commission, the Centers for Medicare & Medicaid Services (CMS), and AAMI. Contact us to start a discussion today.
